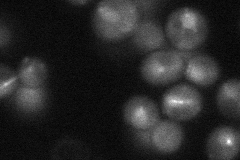
YER016W
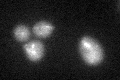
YER016W
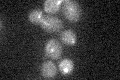
YER016W

View description
Microtubule-binding protein that together with Kar9p makes up the cortical microtubule capture site and delays the exit from mitosis when the spindle is oriented abnormally
Localization:
Intensity:
Fold change:
Significance:
-
C’ GFP library in SD

punctate18.15 -
N' NOP1pr-GFP in SD

punctate97.3983 -
N' TEF2pr-mCherry in SD

punctate,nucleus170.52 -
N' NATIVEpr-GFP in SD
punctate42.6822 -
N' TEF2pr-VC and Cyto-VN in SD

nucleus51.2527 -
C’ GFP library in SD+DTT
punctate20.351.12No -
C’ GFP library in SD+H2O2
punctate19.571.07No -
C’ GFP library in Starvation Media

punctate16.610.91No -
C’ GFP library on the background of Pup2-DaMP

punctate -
C’ GFP library on the background of CCT mutant

punctate19.46441.07178No
